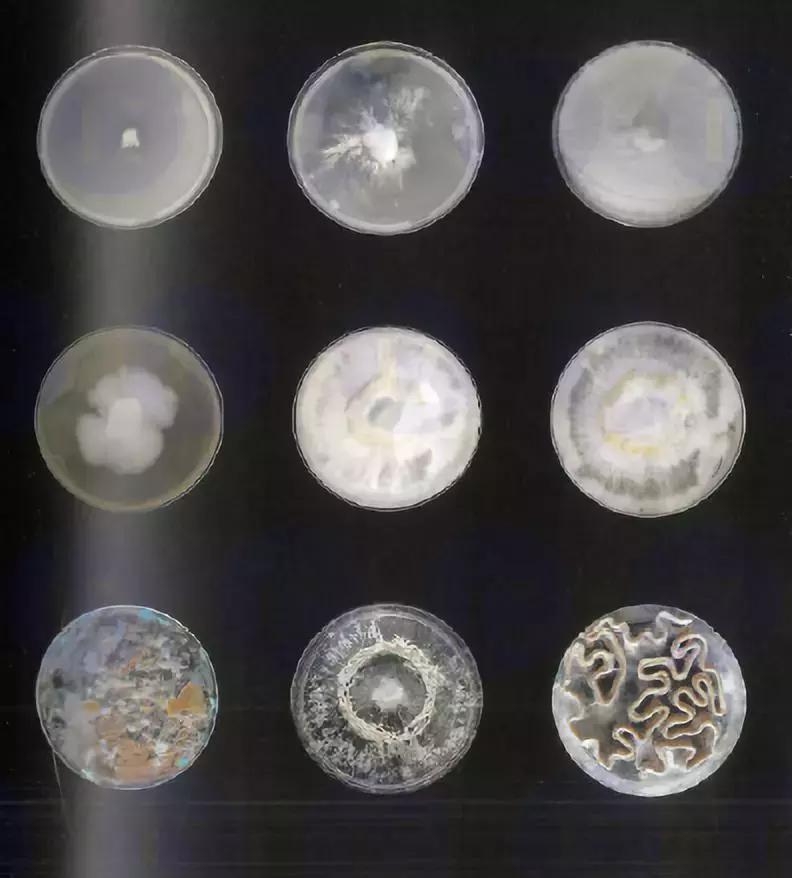
你要的巴特莱特AD专业9组毕业作品，都在这里了！—一沙分享

建筑、景观专业同学肯定都听说过英国UCL巴特莱特建筑学院(The Bartlett)。巴特莱特强调的是如何通过对结构,材质,以及理念的革新的思考去学习建筑,而不是简单的为了修房子去学习建筑。
那你知道2018年AD专业毕业生在研究什么吗?
你一定不知道

巴特莱特建筑学院
巴特莱特建筑学院(The Bartlett)隶属于伦敦大学学院(UCL),伦敦大学学院是一所誉满全球的顶尖名校,而巴特莱特建筑学院则是伦敦大学学院最负盛名的学院之一,也是世界公认最顶尖最具影响力的建筑学院之一。

巴特莱特建筑学院为伦敦大学学院11个组成学院之一。 巴特莱特建筑学院是英国最早的建筑院校,在2014年发布的7年一次的英国官方RAE/REF学术评估中,UCL巴特莱特建筑学院在学术实力排名中雄踞榜首。在2017年QS世界大学建筑学专业排名中,巴特莱特学院位列欧洲第一,全球第二,仅次于麻省理工建筑学院。

巴特莱特AD专业
巴特莱特建筑学院AD(Master of Architectural Design)专业每年录取人数大概为100-120人左右,学院风格主要是跨学科领域的研究。希望通过对于其他领域在建筑上的运用,来拓展建筑设计的边界。

Master of Architectural Design(AD)申请:
模式和持续时间全职: 1年申请日期开放时间:2018年10月15日关闭:2019年7月26日学费海外: £28,410入学要求通常至少是英国大学的二等学士学位或同等标准的海外资格,或者适合该课程的学科的较低分类,以及在高级水平的该领域的广泛专业经验。一旦收到完整的申请,考生将被要求提交他们的设计作品组合,并且在被要求之前不应发送或上传作品。

巴院AD专业一共9个组,分为research cluster 1 -9,在每年学年开始的时候,学生需要对这9个组进行选组。在选组方式上主要以老师与学生双向的选择,即老师介绍自己的研究方向已经一整年的教学计划,学生对于自己的感兴趣的组进行选择。
去年一共有5个志愿可以填写,一般情况下会录取前3个志愿。如果没有被选到前三志愿,建议学弟学妹们第一时间和系主任沟通,表达出你想去某个组的意愿,如果仍旧落选,需要参加第二轮选拔。

技术课
在技术课选课上,每年都有齐全的软件课提供给学生,例如:Maya, Indesign, Illustrator, Photoshop等等,如果觉得软件技术不行,可以选特定的课程来提升自己。
上课模式
上课模式并不是上大课的形式,而是老师带学生的模式,老师把握大的研究方向,学生通过工作小组的形式,将目的实现出来。每个星期学生需要向老师汇报项目进度,还有两次大的汇报,学院会邀请各个组的老师或者业界大佬对你的项目进行点评,尤其是在第三学期的最后的汇报中,电讯派大师同时也是学院创始人Peter Cook 会参与你的项目点评。
硬件设备
在硬件设备上,学校地下有个B-made工作室,有各类设备提供给学生做模型,例如:机械臂,激光切割机,CNC,3D打印等等,工作室的员工会协助学生如何做模型。
2018年毕业生1-9组方向解析
RC1-AI Architecture(人工智能建筑)
方向:通过一定的生成规则,在两个面之间生成优化过的支撑结构。
RC1将人工智能引入到建筑设计中,希望在两个面之间,通过电脑的分析与计算,来自动生成最优的结构。该组主要用到的软件:Processing, Rhino, Grasshopper。


RC3-Living Architecture(自适应建筑)
方向:杆件连接在绳索上,在各个方向上平衡力之后,形成一个没有柱子的稳定结构,同时这个结构还能运动。
RC3去年的研究项目是基于美国宇宙航天局NASA的登陆火星计划,他们希望建筑能够自我适应各种极端环境,他们将建筑看作一个单元组件,同时这个单元组件能够自我组合和适应火星的极端环境。该组主要用到的软件:Unity。


R C4-Computation Lab(计算机实验室)
方向:设计单个或者几个单元体,通过在数量方向上的变化,组合成不同形式的形体,并且能够自动化或者快速装配起来。
RC4每年都是热门组,由于系主任执教这个组,各类资源会相对比较多一些,例如导师团队中Vicente巴院软件主管,机械臂,代码样样精通,在软件上对于学生会有强有力的支持。


RC5/6- Material Lab (材料实验室)
方向:RC5和RC6共同研究材料属性,通过对特殊材料以及制造工艺的研究,以手工或者数字化的方式制造。
RC5和RC6以合作的方式,也是每年的热门组,尤其是合作组的话可以共享导师资源,该组每年对各种特殊材料或者各种建造方式的研究,来探讨这些材料在建筑上运用的可能性。


RC7-Bio Lab(生物实验室)
RC7每年关注的是可持续建筑,通过计算机模拟生物原理,以达到建筑与生物共生的状态,并且通过数字化制造的方式制造。

RC8-Multi-Material(混合材料)
方向:消除建筑之间的连接件,避免组件之间的缝隙,让结构能够从一种材料到另一种材料自然过渡。
RC8 去年希望能够消除建筑构建之间的连接件,例如螺栓,螺帽等,因为建筑连接件会导致各类问题,例如冷热桥。8组希望能够通过材料之间的自然过渡,让建筑构建一体化。


RC9-Augmented Reality(增强现实)
方向:通过增强现实技术来实现数据可视化,从而消除2D图纸的闲职,增强人工建造的精确度。
R9运用微软AR设备Hololens,用户带上Hololens中,可以同时看到虚拟与现实,通过这样的技术,来指导人工建造。



所有学生作品都需要参加B-pro展,将所有模型放在一起,做一个为期7天的开放性展览,每年都会吸引业界各类大佬来参观。


B-Pro展览
建筑设计作品集建议
作品集逻辑
通过对这些组的介绍,相信大家对这些组有了一个初步的认识。大家在准备作品集的过程中,一定要注意作品集逻辑的表达,UCL在整个做项目的过程中,非常注重你的过程,当做这一步的时候需要想清楚为什么做这一步,做这一步对你的设计有怎么样的影响,导致的结果是什么。
一般我们做作品集的逻辑是现状分析-解决策略-形体演变-方案表达-再分析,很多同学在做作品集的过程中都会有逻辑上的断层。例如在解决策略上,同学们经常会将网上看到的方法生搬硬套过来,并没有结合当地的实际情况去做。再比如解决贫困区的居住问题中,很多同学会利用集装箱,但是当你在用集装箱的时候,需要想清楚为什么运用它,如果地块在港口,那我们是可以利用港口废弃的集装箱,所以要结合当地的情况去想解决策略。

竞赛
对于低年级的同学,鼓励大家去做一些竞赛,比如霍普杯,建筑新人站,UA竞赛等等。做竞赛的目的不是为了拿奖,而是能够督促你自己,在短时间内快速地提升自己,并且竞赛项目和作品集类似,在立意上比普通的课程设计更高一些,都比较注重逻辑的表达,所以这可以作为后期作品集项目的一个贮备。
同时也可以对这些组有针对性的进行制作作品,例如系主任组,主要研究的是离散建筑,通过设计单个或者多个单元体,在数量以及方向上的变化,组合成不同的建筑。还可以做一些材料的研究等等,同时在ps中,你可以提到对于UCL的某一个组特别感兴趣,并且介绍你为什么感兴趣,那招生官会觉得你对UCL还是比较了解的,这样对你的申请会有一定的帮助。

喜欢的小伙伴赶紧关注收藏起来!更多干货不定期分享!
头条号:一沙国际创意教育
微信公众号:instart_edu
欢迎━(*`∀´*)ノ亻!大家关注哦